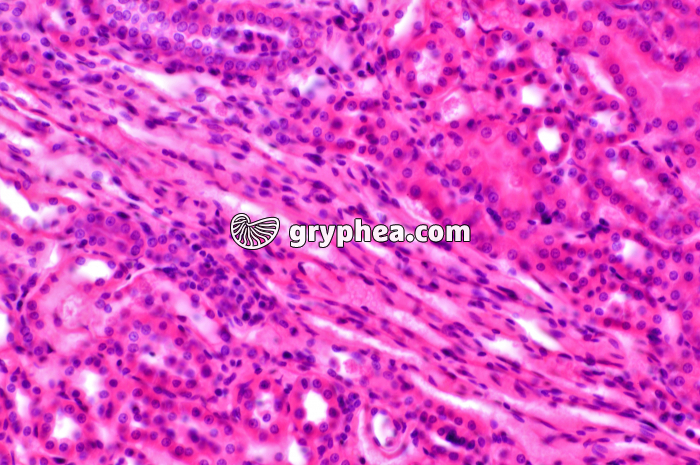
Tubules Rein x100 - gryphea.com

1 crédit = 6.00€ TTC
(Hors pack)
si vous êtes enseignant, le site gryphea.org a été conçu spécialement pour vous !
Organes chargés de l’excrétion de l’urine chez les Vertébrés, les reins permettent la régulation de l’équilibre hydrique et électrolytique de l’organisme. Ils assurent également un rôle dans l’élimination des substances toxiques, dans la régulation de la pression sanguine, et un rôle hormonal.
Sur le plan histologique, le rein présente une zone corticale périphérique, renfermant de grandes quantités de glomérules et des tubules associés, une zone médullaire plus profonde, et, en position centrale, des calices qui collectent l’ensemble de l’urine produite. Le bassinet correspond à un tube en forme d’entonnoir, qui recueille l’urine et la dirige vers les uretères, canaux qui amènent celle-ci dans la vessie.
La suite du commentaire est réservée aux inscrits, créez un compte gratuitement.